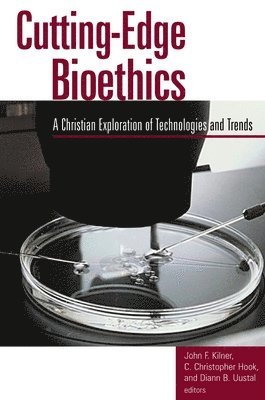

John F. Kilner – författare
211 kr
Skickas inom 5-8 vardagar
140 kr
Läs direkt efter köp
In a world where incredible medical technologies are possible … does “can do” mean “should do”? Why the Church Needs Bioethics helps you understand and constructively engage bioethical challenges with the resources of Christian wisdom and ministry. Three rich and true-to-life case studies illustrate the urgency of such bioethical issues as reproductive and genetic technologies, abortion, forgoing treatment, assisted suicide, stem cell research, and human enhancement technologies. Leading Christian voices bring biblical and theological perspective to bear on the incredible medical technologies available today; mobilize useful insights from health care, law, and business; and demonstrate the powerful ways the church can make a difference through counseling, pastoral care, intercultural ministry, preaching, and education. This book equips students, church and lay leaders, and people in health-related fields with the knowledge to make faithful bioethical decisions and to help foster a world where human beings are shown respect as people created in the image of God. Contributors to Why the Church Needs Bioethics include leading Bible and theology scholars, such as D. A. Carson and Kevin Vanhoozer; leaders in the areas of preaching (Greg Scharf) and ethics (Scott Rae); and 15 other experts in the fields of biblical-theological studies, ministry, communication, business, law, healthcare, and bioethics.
377 kr
Skickas inom 3-6 vardagar
307 kr
Skickas inom 3-6 vardagar
333 kr
Skickas inom 3-6 vardagar
361 kr
Skickas inom 3-6 vardagar
309 kr
Skickas inom 5-8 vardagar
427 kr
Skickas inom 3-6 vardagar
257 kr
Läs direkt efter köp